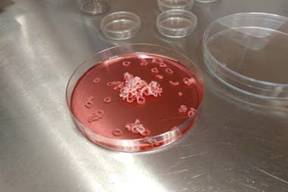
Debido a su tendencia innata a contraerse, las células forman anillos

En el país del bife resulta inimaginable que pueda fabricarse carne animal en un laboratorio, pero una empresa argentina ya lo logró. En pleno corazón de Caballito, el laboratorio Craveri desarrolló una carne cultivada que no es sintética ni vegetal. Es carne vacuna, solo que la empresa no necesitó criar ni sacrificar a ninguna vaca.
La primera vez que este tipo de desarrollo se presentó al mundo fue hace seis años, cuando la firma holandesa Mosa Meat creó la primera hamburguesa de carne cultivada que valía 250.000 euros.
 |
La carne cultivada del laboratorio Craveri tiene el aspecto de pequeños anillos del tamaño de una perla y, según informaron, para fabricar una hamburguesa de 100 gramos, se necesitan entre cuatro y cinco semanas de cultivo. Sin embargo, aún no están en esa etapa de desarrollo.
Los anillos son carne
Bajo la premisa de "Comé carne, no animales", la empresa utiliza técnicas de cultivo para desarrollar un sustituto de la producción de carne tradicional e invitaron a un reducido grupo de periodistas a conocer cómo se elabora este tipo de carne. Cuando en 2016 Juan Craveri, titular de la empresa, decidió incursionar en la carne cultivada, su laboratorio ya llevaba 20 años investigando la tecnología de cultivo para la multiplicación de células.
La inversión principal ya había sido desembolsada y ascendía a más de un millón de dólares. La planta ya estaba montada, por lo que para desarrollar la carne invirtió alrededor US$200.000. Así nació Bife, cuyas siglas significan Bioingeniería en la Fabricación de Elaborados. De las 320 personas que trabajan en el laboratorio, ocho se dedican al proyecto Bife.
Cómo se elabora la carne cultivada
Para comenzar el proceso de elaboración, se extraen muestras de animales de un campo en Atalaya. "Para el cultivo elegimos animales jóvenes, porque el potencial para dividirse y crecer de sus células es mayor", explicó Diego Dominici, bioquímico miembro de Bife. La biopsia es extraída del músculo sóleo del animal y tiene el tamaño de una pastilla de Tic tac, es decir, alrededor de cinco milímetros.
 Desde el laboratorio informaron que se trata de un procedimiento rápido, inofensivo y bajo anestesia. La muestra se traslada al laboratorio en un kit de transporte en un medio de cultivo. Una vez que llega, el primer paso es la disgregación mecánica en una cabina de bioseguridad, es decir, se aísla a las células satélites, que luego son transferidas a un medio que contiene nutrientes y factores de crecimiento que permiten proliferar a las células como lo harían en el interior de un animal.
Desde el laboratorio informaron que se trata de un procedimiento rápido, inofensivo y bajo anestesia. La muestra se traslada al laboratorio en un kit de transporte en un medio de cultivo. Una vez que llega, el primer paso es la disgregación mecánica en una cabina de bioseguridad, es decir, se aísla a las células satélites, que luego son transferidas a un medio que contiene nutrientes y factores de crecimiento que permiten proliferar a las células como lo harían en el interior de un animal.
La elaboración del producto en el laboratorio
La solución donde se reproducen es cambiada cada 48 horas. "Liberamos las células y las pasamos a ambientes controlados con estufas de cultivo para que aumenten en número. Simulamos un ambiente similar al cuerpo para que la célula piense que está en el cuerpo y se reproduzcan. Las células las combinamos con un gel de kitosano", explicó Dominici.
 |
Las células proliferan hasta obtenerse trillones de ellas. Estas células cultivadas se fusionan naturalmente hasta conformar estructuras que se llaman miotúbulos de 0,3 mm. Luego, esos miotúbulos se colocan en un soporte adecuado y, debido a su tendencia innata a contraerse, forman anillos. "Este anillo es carne", expresó Dominici.
Bajo la premisa de "Comé carne, no animales", utilizaron técnicas de cultivo para desarrollar un sustituto de la producción de carne tradicional Crédito: Laboratorios Craveri
Por el momento, desde el laboratorio están en una etapa de desarrollo, por lo que ninguno de los involucrados probó todavía la carne cultivada. Sin embargo, aseguraron que en el mundo solo 50 personas degustaron este tipo de producto.
"La carne cultivada no es ciencia ficción y se está creando una nueva era que es la agricultura celular", dijo el titular de la empresa, quien señaló que tanto la población mundial como el consumo cárnico aumentan y que no hay suficiente espacio para la actividad ganadera.
"La carne cultivada no es ciencia ficción y se está creando una nueva era que es la agricultura celular", dijo el titular de la empresa, quien señaló que tanto la población mundial como el consumo cárnico aumentan y que no hay suficiente espacio para la actividad ganadera.
"La población crece a gran velocidad, pero la capacidad del planeta para producir es limitada", añadió. Craveri aseguró que la carne cultivada en laboratorio permite un ahorro del 45% en energía, requiere un 99% menos de terreno y, según dijo, reduce un 96% la emisión de gases de efecto invernadero. Además, utiliza un 96% menos de agua.
Las células cultivadas se fusionan naturalmente hasta conformar miotúbulos de 0,3 mm Crédito: Laboratorio Craveri
La carne cultivada no está modificada genéticamente, sino que es producto de la multiplicación in vitro de las mismas células que producen la carne en el animal. Se trata de una innovación. Aunque existen otros proyectos en el país que están investigando este desarrollo, desde la empresa aseguraron que se encuentran varios "pasos por detrás de ellos".
 |
No obstante, Craveri contó que faltan entre cinco y diez años para que la carne cultivada sea comercializada. "Estamos tratando de desarrollar la monetización. Nadie invierte sólo por filantropía desde una empresa privada sino no es sustentable", dijo.
Laura Correa, la coordinadora de la División Bioingeniería del laboratorio, explicó que para poder comercializar primero necesitan alcanzar una escala industrial que baje los costos y que exista una regulación estatal que permita su consumo. Además, afirmó que una segunda etapa implica el trabajo con un chef para innovar en texturas y sabores.
Desde la empresa indicaron que a nivel nutricional es como la carne tradicional, pero tiene como ventaja que desde el laboratorio se pueden alterar la nutrición, la grasa e incluso agregar vitaminas y minerales. El proceso de cultivo involucra el aislamiento de las células satélites
Prometen una hamburguesa de carne de laboratorio por 10 dólares para 2022
La carne cultivada en laboratorio, presentada al mundo por primera vez hace 6 años en la forma de hamburguesa de 280.000 dólares, podría llegar a los estantes de supermercados con un valor de 10 dólares por unidad dentro de dos años, le dijeron empresas europeas a Reuters.
 Consumidores preocupados por el cambio climático, el bienestar de los animales y su propia salud están fomentando el interés en la llamada carne limpia, y la cantidad de nuevas empresas asociadas trepó desde cuatro a fines del 2016 a más de dos decenas dos años después, según un estudio de mercado de The Good Food Institute (GFI por si sigla en inglés).
Consumidores preocupados por el cambio climático, el bienestar de los animales y su propia salud están fomentando el interés en la llamada carne limpia, y la cantidad de nuevas empresas asociadas trepó desde cuatro a fines del 2016 a más de dos decenas dos años después, según un estudio de mercado de The Good Food Institute (GFI por si sigla en inglés).
Carne sintética: qué es y cómo se prepara
La alternativa de la carne de origen vegetal también está en auge. Las acciones de Beyond Meat han más que triplicado su valor desde su oferta pública inicial en mayo. Beyond Meat e Impossible Foods vendieron el 100% de su carne vegetal a minoristas y cadenas de comida rápida en Estados Unidos.
La carne cultivada a partir de células animales podría ser lo siguiente en el menú, debido a que sus productores buscan las aprobaciones de reguladores mientras mejoran su tecnología y reducen los costos.
Mark Post, de la universidad de Maastricht, en 2013 al presentar la primera hamburguesa hecha con carne de laboratorioArchivo
 |
El cofundador de la firma holandesa Mosa Meat, Mark Post, creó la primera hamburguesa de carne "cultivada" el 2013, con un costo de 250.000 euros (280.400 dólares), financiada por el cofundador de Google, Sergey Brin. Sin embargo, Mosa Meat y la española Biotech Meats dicen que los costos de producción han disminuido drásticamente desde entonces.
"La hamburguesa era así de cara el 2013 porque en ese entonces era una ciencia nueva y estábamos produciéndola a muy pequeña escala. Una vez que la producción aumente, proyectamos que el costo para producir una hamburguesa sería de alrededor de 9 euros", dijo una portavoz de Mosa Meat a Reuters, agregando que podría llegar a ser incluso más barata que una hamburguesa convencional.
La cofundadora de Biotech Foods, Mercedes Vila, también destacó la importancia de pasar del laboratorio a la fábrica. "Nuestro objetivo es alcanzar una producción a escala y tener la aprobación regulatoria para 2021", dijo Vila.
Agregó que el costo de producir un kilo de carne cultivada en laboratorio era de unos 100 euros, monto significativamente menor a los 800 dólares citados hace un año por Future Meat Technologies, una firma de biotecnología israelí que ha recibido financiamiento de la procesadora de carne estadounidense Tyson Foods.
La carne cultivada en laboratorio: la opción alimentaria del futuro
 Con la producción de carne artificial se busca una opción que provea de proteína de origen animal a la dieta de los seres humanos, que sea amigable con el medio ambiente y sin el costo del animal
Con la producción de carne artificial se busca una opción que provea de proteína de origen animal a la dieta de los seres humanos, que sea amigable con el medio ambiente y sin el costo del animal
Con la producción de carne artificial se busca una opción que provea de proteína de origen animal a la dieta de los seres humanos, que sea amigable con el medio ambiente y sin el costo del animal. Sin embargo, por el momento esta innovación está en fase experimental y no se concretará en el corto plazo, afirmó María Rubio, académica de la Facultad de Medicina Veterinaria y Zootecnia (FMVZ) de la UNAM.
"Puede ser una opción alimentaria a futuro; es una industria en desarrollo y hay muchas personas que creen en ella. Más de 200 empresas en el planeta apoyan o están interesadas en investigaciones que buscan hacer de la carne artificial un proyecto viable, eficiente y eficaz".
Se han logrado avances importantes para obtener carne cultivada (in vitro); diversos grupos de investigación en el mundo intentan solventar las barreras tecnológicas para que este desarrollo pueda escalar y se haga de forma eficiente, pero por el momento la carne artificial no es una opción real, reiteró.
"Hasta ahora se han elaborado tres hamburguesas de res cultivando células satelitales de tejido muscular de bovino, pero el proceso se ha realizado cosechando cada fibra muscular de manera individual, proceso largo y costoso (un millón de euros)", indicó
 |
En Israel hay empresas que investigan cómo producir carne de pollo; en Estados Unidos el enfoque es para cultivar las de bovino y cerdo; y en Europa buscan la de bovino. "Puede ser de cualquier tipo, porque se puede crear in vitro a partir de las células satelitales del tejido muscular de cualquier animal", explicó.
Varios grupos apoyan y financian estos proyectos: los veganos, vegetarianos y quienes se oponen a la explotación y matanza de animales para comer; también hay gobiernos e instituciones privadas que otorgan ayuda para estas investigaciones. Pero por otro lado está el sector cárnico tradicional de EU y países europeos.
Desafíos
Son muchos los retos que deben enfrentarse; por ejemplo, cuando se cultivan las células musculares es necesario darles suero y éste también debe sacarse de animales, lo cual contraviene las premisas de quienes no quieren que se use a éstos para alimentar a los humanos; además, hoy en día el suero es un producto costoso.
Entre los mayores desafíos está conseguir que la prolificidad de las células satelitales sea prolongada. Por el momento, cuando se cultiva una célula satelital de músculo de bovino sólo puede dividirse entre nueve y 12 veces, lo que hace este proceso poco eficiente para obtener muchos kilos, explicó.
La medicina regenerativa, el origen
 La especialista en ciencia de la carne recordó que fue el holandés Mark Post quien comenzó con estos experimentos, hace 10 años. "Estuve un tiempo en su laboratorio, donde sólo se trabaja con bovinos; el proceso de cultivo empieza con la extracción de un trozo de carne después de la muerte del animal".
La especialista en ciencia de la carne recordó que fue el holandés Mark Post quien comenzó con estos experimentos, hace 10 años. "Estuve un tiempo en su laboratorio, donde sólo se trabaja con bovinos; el proceso de cultivo empieza con la extracción de un trozo de carne después de la muerte del animal".
La obtención de carne artificial se sustenta en los principios de la medicina regenerativa. "Desde hace años se descubrió que los animales tienen células madre, llamadas 'satelitales', en la mayoría de sus tejidos, con un potencial de proliferación muy alto y poca especificidad". Su cultivo, aunado a la ingeniería de tejidos, ha servido para regenerar tejidos en pacientes con problemas degenerativos y otras patologías.
Esto llevó a los holandeses a pensar que si se podían regenerar los tejidos para ayudar a los humanos, también se podía aplicar un proceso similar con el tejido muscular de animales comestibles para crear carne in vitro.
"Entonces tomaron células de tejido muscular de un bovino y las cultivaron hasta crear una hamburguesa".
Fuentes: https://www.infobae.com/america/mexico/ BBC Mundo
https://www.elespanol.com/invertia/disruptores-innovadores/innovadores/ https://www.lanacion.com.ar/tecnologia/Por: Catalina Bontempo
Por APIE: Andrea Carolina Monzon RRPP/RI Secretaria de Redaccion
Boletín APIE Informa www.apie.com.ar // info@apie.com.ar - ![]() @apie.ingenieros
@apie.ingenieros
Jujuy 441 - 5ºP. -Tels: (54) (0351) 4236074 - 4220081/46
CP: 5000 - CORDOBA - ARGENTINA
E-mail: info@apie.com.ar